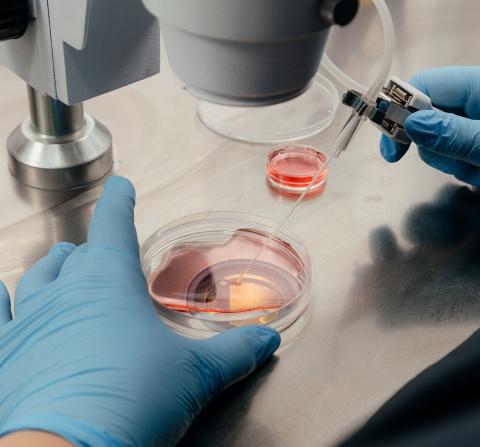

Каталог доноров
ЭКО с донорскими эмбрионами
Эмбрионы для донорства могут быть получены в результате оплодотворения донорских ооцитов донорской спермой или переданы в донацию пациентами клиники ЭКО.
Показания к применению донорских эмбрионов:
·
отсутствие у партнеров собственных половых клеток
·
высокий риск развития наследственных заболеваний
·
неоднократное получение эмбрионов низкого качества, перенос которых не приводит к наступлению беременности (при 3-х и более попытках программ ВРТ).
Пациентам предоставляется вся необходимая информация о донорах. В каталоге «Центр ЭКО» отдельно выделены эмбрионы с подтвержденным генетическим статусом.
Перенос проходит в рамках программы «Криоперенос».